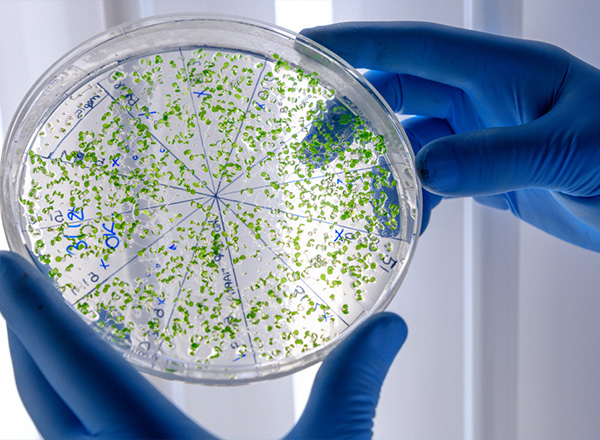
Biyositler

Kimyasallar
Power Endüstri Mühendislik
Power Endüstri Mühendislik
Kimyasallar
Endüstriyel kimyasallar tedarikinde iş ortaklarımız ile kurduğumuz güçlü bağlar sayesinde size en doğru çözümleri sunmaya devam ediyoruz. Hem sektördeki alanlarımızı genişleterek hem de yeni iş ortaklarımızla kurduğumuz yeni birliktelikler ile hedefimiz; müşterilerimizin taleplerine en uygun çözümleri istenilen kalitede, tam zamanında ve alternatif çözümler sunarak; verimli ve sürdürebilir bir büyümeyi sağlamaktır.
- Temel Kimyasallar
- Labaratuvar Kimyasalları
- Su Filtrasyon Araçları Antrasit
- Biyositler
- Koagülantlar Flokülantlar
- Aktif Karbon
- Taş Önleyiciler Antiskalant
- İyon Değiştirici Reçineler
- Su Atıksu Şartlandırma Kimyasalları / Ekipmanları
- Köpük Kesiciler

Power Endüstri Mühendislik